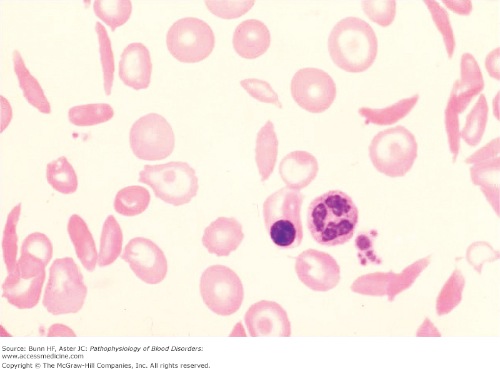
<ul><li><p>a genetic disorder </p><ul><li><p>autosomal recessive condition. </p></li></ul></li><li><p>Under certain conditions, RBCs that are normal in shape will sickle and this will cause them to get stuck in capillaries. </p></li><li><p></p></li><li><p>Symptoms/episodes that occur </p><ul><li><p>joint and chest pain</p></li><li><p>numbness in the hands and feet</p></li><li><p>jaundice</p></li><li><p>frequent infections</p></li><li><p>sores on the skin</p></li><li><p>delayed growth</p></li><li><p>stroke</p></li><li><p>seizures</p></li><li><p>breathing difficulties</p></li><li><p>Retina damage</p><ul><li><p>causes vision problems, </p></li></ul></li><li><p>damage to </p><ul><li><p>spleen</p></li><li><p>liver</p></li><li><p>kidney </p></li><li><p>lung damage </p></li></ul></li></ul></li><li><p>no cure for sickle cell disease</p></li><li><p>it can be treated or managed with </p><ul><li><p>antibiotics</p></li><li><p>blood transfusions</p></li><li><p>pain medications</p></li><li><p>bone marrow transplants</p></li><li><p>supplemental oxygen</p></li><li><p>medications to promote the development of normal hemoglobin.</p></li></ul></li></ul><p></p>
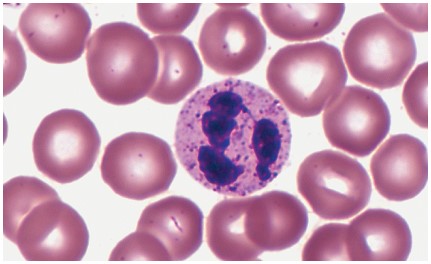
<ul><li><p>account for about 60 percent of the WBC count. </p></li><li><p>They have a nucleus with three to five lobes </p></li><li><p>have phagocytic qualities. </p></li><li><p>They are important in </p><ul><li><p>the destruction of bacteria </p></li><li><p>their numbers increase in the early stage of acute inflammation.</p></li></ul></li></ul><p></p>
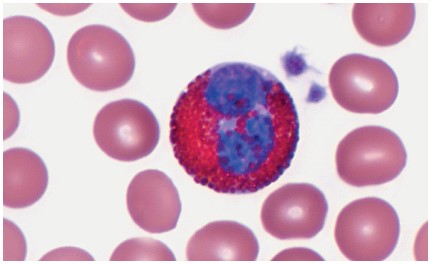
<ul><li><p>account for about 3 percent of all WBCs. </p></li><li><p>They have reddish-orange cytoplasmic granules </p></li><li><p>are involved in fighting parasitic infections </p></li><li><p>increased in number in people with acute or active <strong>allergies</strong>.</p></li></ul><p></p>
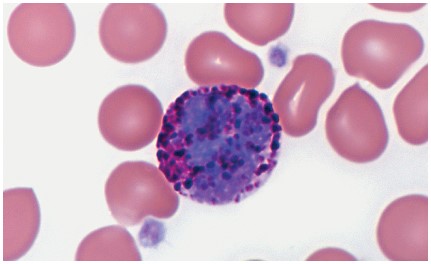
<ul><li><p>account for less than 1 percent of all WBCs</p></li><li><p>They have purplish-black cytoplasmic granules </p></li><li><p>release substances such as </p><ul><li><p>histamine, </p><ul><li><p>promotes inflammation, </p></li></ul></li><li><p>heparin</p><ul><li><p>is an anticoagulant.</p></li></ul></li></ul></li></ul><p></p>
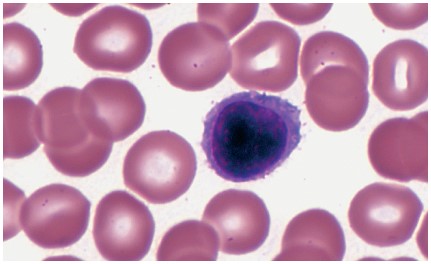
<ul><li><p>account for about 30 percent of all WBCs</p></li><li><p>participate in immunity</p></li><li><p>are white blood cells with large nucleus and small rim of cytoplasm</p></li><li><p>they play an important role in the </p><ul><li><p>lymphatic system </p></li><li><p>immune system.</p></li></ul></li></ul><p></p>

1/101
Looks like no tags are added yet.
Name | Mastery | Learn | Test | Matching | Spaced |
|---|
No study sessions yet.
Blood makeup of the body
average-sized adult body contains approximately 4 to 6 liters of blood
approximately 8 percent of the total body weigh
varies from person to person depending on
person’s size
the amount of adipose tissue
concentrations of certain ions in the blood
Blood essential functions
It carries oxygen and nutrients to tissues and carbon dioxide and wastes away from tissues.
It also acts as the transport mechanism for hormones and helps with heat regulation of the body.
The process of transporting blood to and from the body tissues is known as circulation.
The heart’s powerful muscular pump performs the task of circulation.
primary function of blood
deliver oxygen and nutrients to
remove wastes from body cells.
Also include
defense (protection)
distribution of heat
maintenance of homeostasis (regulation).
Blood as a connective tissue
It is a connective tissue
it is made up of cellular elements and an extracellular matrix
The cellular elements of bloods
- termed the formed elements
include
red blood cells (RBCs)
white blood cells (WBCs)
cell fragments called platelets.
The extracellular matrix of blood
called plasma
makes blood unique among connective tissues because it is fluid
mostly water
suspends the formed elements
enables them to circulate throughout the body within the cardiovascular system.
Blood function for Transportation
Deliver oxygen we breathe from the lungs to the heart and nutrients from the digestive system to all body cells.
Transport hormones from the endocrine glands into the bloodstream, which carries them to the target cells.
Blood also picks up cellular wastes and byproducts and transports them to various organs for removal.
For instance
blood moves carbon dioxide to the lungs for exhalation from the body,
various waste products are transported to the kidneys and liver for excretion from the body in the form of urine or bile.
Blood function for Defense (Protection)
Prevent Infection:
WBCs protect the body from disease-causing bacteria that have entered the bloodstream in a wound.
WBCs like lymphocytes seek out and destroy internal threats, such as
cells with mutated DNA that could multiply to become cancerous,
body cells infected with viruses
Prevent Blood Loss:
When damage to the vessels results in
bleeding
platelets and plasma protein
initiate clot formation
halting further blood loss.
Blood functoin of Maintenance of Homeostasis (Regulation)
Maintaining body temperature by
absorbing and distributing heart throughout the body
and to the surface of the skin to encourage heat loss.
In contrast, on a cold day, blood is diverted away from the skin to maintain a warmer body core.
In extreme cases, this may result in frostbite.
Maintain the chemical balance of the body.
Proteins and other compounds in blood act as buffers,
help to regulate the pH of body tissues.
regulate the water content of body cells and the circulatory system.
Hematopoiesis
formation of blood cells from
stem cells
both red and white
Location of Hematopoiesis in fetal development (Early Life stages)
Blood cells made in the
yolk sac
liver
spleen.
Location of Hematopoiesis in After birth (Later Life stages)
blood cells are produced in
red bone marrow by stem cells
called hemocytoblasts.
average life span of an RBC
120 days, so red bone marrow is constantly making new cells.
hormone erythropoietin
responsible for regulating erythropoiesis or the production of RBCs.
is produced by the kidneys
released by the kidneys when oxygen concentrations in the blood get low.
stimulates the red bone marrow to produce new RBCs.
dietary factors that affect RBC production.
Vitamin B12 (major dietary factor)
requires intrinsic factor to be absorbed
absorbed from small intestine
Function for DNA synthesis
folic acid (major dietary factor)
absorbed from small intestine
Iron
required to make hemoglobin
Absorbed from small intestine
conserved during RBC destruction to be reused

some causes of anemia
Too few RBCs
too little iron
too little hemoglobin
insufficient vitamin B12
Plasma
straw colour liquid portion of blood
90% water
contain many different dissolve solutes, including
nutrients
gases
hormones
protein
electrolytes
waste and products of cells activity.
three major types of proteins found in plasma:
Albumins
Globulins
Fibrinogen
Albumins (major plasma protein)
smallest of the plasma proteins,
most abundant plasma proteins
account for about 60% of plasma protein.
produced by the liver
are responsible for the osmotic pressure in blood vessels
along with hydrostatic pressure
control movement of water between blood vessels and the tissues.
transport
hormones
some drugs
free fatty acids
bilirubin.
Function
Helps maintain colloid osmotic pressure
Globulins (major plasma protein)
36 % of plasma proteins
proteins produced by
liver plasma cells
specialized blood cells
(lymphatic tissue)
Some types of globulins are involved in
lipid transport
those produced by plasma cells are antibodies
work as part of the immune system
Alpha globulins
Origin: Liver
Function
Transport lipids and fat-soluble vitamins
Beta globulins
Origin: liver
Function
Transport lipids and fat-soluble vitamins
Gamma globulins
Origins: Lymphatic tissues
Function
Antibodies (immunoglobulins)
Fibrinogen (major plasma protein)
Origin: liver
4 % of total protein plasma
Is a protein important in blood clotting.
The term serum is used for the fluid that is left when all clotting factors are removed from plasma.
Function
Plays a key role in blood
coagulation
serum
the fluid that is left when all clotting factors are removed from plasma
free of Fibrinogen
Nutrients in plasma
amino acids
glucose
nucleotides
lipids that have all been absorbed from the digestive tract.
lipoproteins
Lipids transported throught the blood (specifically blood plasma)
lipids are not water soluble and because plasma is mostly water, lipids must combine with molecules called lipoproteins to be transported by plasma.
different types of lipoproteins are chylomicron,
3 Types
very low-density lipoproteins (VLDL)
low-density lipoproteins (LDL)
high-density lipoproteins (HDL).
Gases dissolved in plasma
oxygen
carbon dioxide
nitrogen
Electrolytes dissolved in plasma
sodium
potassium
calcium
magnesium
chloride
bicarbonate
phosphate
sulfate
Nonprotein nitrogenous substances in plasma
amino acids
urea
uric acid
The formed elements of blood are (Cellular Components)
erythrocytes
leukocytes
platelets
Erythrocytes (RBCs; cellular component of blood)
are small cells that have a biconcave shape.
Mature RBCs do not have a nucleus and consequently cannot reproduce themselves.
contain a pigment called hemoglobin
function is to bind to oxygen and transport it to the tissues.

hematocrit
percentage of red blood cells in relationship to the total blood volume
normal hematocrit in males
43 to 49 L/L in males
normal hematocrit female
is about 37 to 43 L/L
Centrigufation of blood
the heavier red blood cells settle to the bottom and can thus be measured.
The percentage of red blood cells in relationship to the total blood volume is called the hematocrit or packed cell volume.
A normal hematocrit is about 37 to 43 L/L in females and 43 to 49 L/L in males.
On top of the RBCs is the plasma
the lighter component, approximately 55 percent of the total blood volume
Between the RBCs and the plasma is a thin layer that is whitish in color and is called the “buffy coat.”
made up of white blood cells and platelets
make up roughly 1 percent of the total blood volume.

Hemoglobin
is made of red pigment
heme bound to protein globulin
bind to oxygen and transport it to the tissues.
In the lungs, hemoglobin picks up oxygen, which binds to the iron ions
bright red
forming oxyhemoglobin
In the body tissue the process is reversed, where it releases some of the oxygen molecules, becoming darker red
deoxyhemoglobin, sometimes referred to as reduced hemoglobin.
Carboxyhemoglobin refers to hemoglobin that is carrying carbon dioxide.
Normal RBC count
Adults male
5.5 x1012/L of blood
Adult female
4.5 x1012/L of blood.
oxyhemoglobin
In the lungs, hemoglobin picks up oxygen, which binds to the iron ions
bright red color
deoxyhemoglobin
sometimes referred to as reduced hemoglobin
blood that released some of the oxygen molecules
darker red color
Carboxyhemoglobin
refers to hemoglobin that is carrying carbon dioxide.
Anemia (RBC disordeR)
occurs when the blood has less than its normal oxygen-carrying capacity.
occur when the following is less than normal
the red blood cell count
hemoglobin concentration, is less than normal.
Normal in Men:
13.8 to 17.2 grams/L
Women
2.1 to 15.1 grams/L.
A normal hemoglobin level in men is 13.8 to 17.2 grams/L and in women is 12.1 to 15.1 grams/L.
Signs and symptoms of all forms of anemia
tiredness
weakness
pallor
tachycardia
numbness or coldness of the hands and feet,
dizziness
headache
jaundice.
Iron deficiency anemia:
Iron is needed to make hemoglobin, so people with low iron levels often have correspondingly low hemoglobin levels.
The RBC’s are small (microcytes) and pale because they cannot synthesize their normal amount of hemoglobin.
Pregnant women and women with heavy menstrual cycles are most susceptible to this type of anemia.
Others with chronic bleeding conditions are also at risk of developing this type of anemia.
such as
ulcers
colon cancer
Aplastic anemia
When the bone marrow is destroyed
the result is aplastic anemia.
The following can desotry all bone marrow
Chemotherapy and radiation therapy
some cancers and toxins,
Because the bone marrow is destroyed
the number of all formed elements produced by the body is also affected.
Hemolytic anemia:
Red blood cells are destroyed faster than they can be produced.
Example sickle cell disease
Sickle cell disease (a type of hemolytic anemia)
a genetic disorder
autosomal recessive condition.
Under certain conditions, RBCs that are normal in shape will sickle and this will cause them to get stuck in capillaries.
Symptoms/episodes that occur
joint and chest pain
numbness in the hands and feet
jaundice
frequent infections
sores on the skin
delayed growth
stroke
seizures
breathing difficulties
Retina damage
causes vision problems,
damage to
spleen
liver
kidney
lung damage
no cure for sickle cell disease
it can be treated or managed with
antibiotics
blood transfusions
pain medications
bone marrow transplants
supplemental oxygen
medications to promote the development of normal hemoglobin.
Megaloblastic anemia:
Megaloblastic refers to the large red blood cells that are seen in this condition.
caused by deficency of
Vitamin B12 and folic acid
required for the synthesis of erythrocytes
Intrinsic factor is required for absorption of vitamin B12 by the body.
A deficiency of intrinsic factor
a chemical secreted by the parietal cells of the stomach
is responsible for the lack of absorption of vitamin B12 by the gastrointestinal tract.
Thalassemia (a type of anemia)
is an inherited form of anemia
defective hemoglobin molecule
causing
microcytic
red blood cells that are smaller than normal
hypochromic
red blood cells that are paler than normal
short-lived RBCs.
Etiology
hereditary.
Patients of Mediterranean descent are most likely to carry
the defective autosomal recessive gene that causes this disease.
Comes in two forms:
thalassemia major,
severe form of the disease
thalassemia minor,
only minimal symptoms,
considered to be the “carrier” form of the disease.
Signs and Symptoms:
Thalassemia major
is evident in infancy with
anemia
fever
failure to thrive
splenomegaly.
It is confirmed by characteristic changes in RBCs noted on microscopic examination.
As the child matures, splenomegaly may interfere with breathing.
skin becomes freckled or bronzed from the iron deposits created by the rapidly destroyed RBCs.
Headache
nausea
anorexia
Treatment:
There is no cure for thalassemia.
Frequent transfusions are necessary to treat the anemia caused by the destruction of the defective RBCs.
A splenectomy may be recommended to slow the destruction of erythrocytes.
Leukocytes (WBC)
are critical to our defense of disease
Unlike RBCs, all white blood cells contain a nucleus.
Two groups
whether or not they have granules in their cytoplasm
granulocytes
have granules in their cytoplasm
include
neutrophils,
eosinophils
basophils.
agranulocytes
do not have granules in their cytoplasm
include
monocytes
lymphocytes.
Neutrophils (granulocytes)
account for about 60 percent of the WBC count.
They have a nucleus with three to five lobes
have phagocytic qualities.
They are important in
the destruction of bacteria
their numbers increase in the early stage of acute inflammation.
Eosinophils (granulocytes)
account for about 3 percent of all WBCs.
They have reddish-orange cytoplasmic granules
are involved in fighting parasitic infections
increased in number in people with acute or active allergies.
Basophils (granulocytes)
account for less than 1 percent of all WBCs
They have purplish-black cytoplasmic granules
release substances such as
histamine,
promotes inflammation,
heparin
is an anticoagulant.
Lymphocytes (agranulocytes)
account for about 30 percent of all WBCs
participate in immunity
are white blood cells with large nucleus and small rim of cytoplasm
they play an important role in the
lymphatic system
immune system.
A WBC count
is the number of WBCs found in one cubic millimeter of blood
this count is normally between 5.0 and 11.0 X109/L cells.
Leukocytosis
A WBC count that is significantly elevated.
can be caused by
infection
cancer
by some drugs.
It can also occur after eating a large meal or experiencing stress.
Leukopenia
A WBC count below normal
can be caused by
viral infections
congenital bone marrow disorders
cancer
immune disorders
some drugs.
Leukemia (Leukocytes Disorder)
A neoplastic condition in which the bone marrow produces a large number of WBCs that are not normal.
These abnormal cells prevent normal WBCs from carrying out their defensive functions.
Several different kinds of leukemia exist:
acute lymphocytic leukemia
related to lymphs
acute myelogenous leukemia
related to bone marrow
chronic lymphocytic leukemia
chronic myelogenous leukemia.
Etiology:
Causes of leukemia include
mutations in WBCs
via exposure to environmental and chemical agents
chemotherapy for the treatment of other cancers
genetic factors.
Signs and Symptoms:
fatigue
dyspnea on exertio
shortness of breath
hepatomegaly or splenomegaly or both
swollen lymph nodes
abnormal bruising
wounds that heal slowly
frequent infections
nosebleeds
bleeding gums
chronic fever
unexplained weight loss,
excessive sweating.
Treatment:
chemotherapy
radiation therapy,
medications to strengthen the immune system
antibodies to destroy mutated WBCs
bone marrow transplant
stem cell transplant.
Platelet (Thrombocytes)
is not a cell but rather a fragment of the cytoplasm of a cell in the bone marrow called a megakaryocyte.
Megakaryocytes are descended from myeloid stem cells and are large, typically 50–100 µm in diameter, and contain an enlarged, lobed nucleus.
do not have a nucleus and are essential to blood clotting.
When blood vessels are ruptured or their lining is injured, platelets form a temporary plug by sticking to the damaged site.
healthy individuals there are between
130.0 and 360.0 platelets X109/L of blood.
Thrombocytopenia (Disorders of Platelets)
A condition in which there are too few platelets
blood may not clot properly causing excessive bleeding
The bleeding may be mild or life threatening.
can be caused by
leukemia
medications, or even idiopathic reasons.
Thrombocythemia/ Thrombocytosis(Disorders of Platelets)
An increase in the platelet count.
Although in most cases the situation is benign
can cause
serious thrombus
embolus formation
unwanted blood clots both of which can life threatening.
The cause may be
idiopathic
secondary to cancer
hemorrhage
infection
possibly more
Blood Test
Complete blood count (CBC)
Differential Cell Count
Platelet count
Prothrombin time (PT/INR)
Partial Thromboplastin time (PTT)
Special Coagulation Studies e.g. Factor Assay
Iron and Total iron binding capacity studies
Vit B12 and Folic Acid
ABO (blood group) and Rh factor
Blood group antibody test
Reticulocyte count
RBC Electrophoresis
Blood test for various cancer
Various Chemistries and Microbiology tests
Blood Vessels
transport channels through which the blood travels
form a close delivery system that begins and ends at the heart.
The three major types of blood vessels are
arteries
carry blood away from the heart and the blood in them is oxygenated
(an exception is the pulmonary arteries that carry deoxygenated blood to the lungs for oxygenation).
veins
carry blood toward the heart and carry deoxygenated blood
(the exception is the pulmonary veins that carry oxygenated blood from the lungs back to the heart).
capillaries
Arteries and arterioles
deliver oxygen and nutrients to the tissues.
are high-pressure vessels.
Arteries have three layers, or tunics. Listed in order from the most interior layer adjacent to the lumen to the outermost layer
tunica intima
tunica media
tunica externa.

tunica intima (layer of the arteries)
most interior layer
is made up of a single layer of squamous epithelium called endothelium.

tunica media (layer of the arteries)
medial layer
is made up of smooth muscle
is thicker in some arteries than others.
The smooth muscle can cause vasoconstriction or vasodilation.

tunica externa (layer of the arteries)
outermost later
is made up of connective tissue.


Veins and venules
Blood is under much lower pressure in the veins than in the arteries.
Veins also have a
tunica intima
tunica media
is thinner, with less smooth muscle to move the blood along its way. Than arteries
tunica externa.
depend on two mechanisms to return blood to the heart.
One is the pumping action of skeletal muscle such as in the legs.
The other is pressure changes in the thoracic cavity that “draw” blood toward the heart.
Also, veins have valves that work to prevent blood from “falling down” due to gravity as it moves toward the heart.

Capillaries
are the smallest of the blood vessels
RBC pass through them in single file
high preassure, cause blood plasma to leak
called interstitial fluid (exchange site of blood and tissue)
contains
water
nutrients
hormones
gasses
waste
small proteins of blood
They connect arterioles to venules
they are abundant/numerous
have very thin walls
only about one cell layer thick.
The allow substances to easily pass into and out of capillaries.
they are referred to as exchange vessels.
exchanging between tissues
waste
nutrients
gasses
O2 and CO2 readily diffuse in and out
hormones
Have precapillary sphincters that control
the amount of blood that flows into them.
The substances that move through the capillary walls do so through
diffusion
filtration
osmosis.
Because blood is under pressure as it enters the capillary,
water is forced through the capillary wall via filtration.
This allows water to enter a tissue fluid of the body.
By the time blood leaves a capillary, it has a high solid concentration and a low water concentration;
water therefore moves back into the capillary through osmosis.
Water always moves toward the greater concentration of solids, if possible.

Aneurysm (circulation disorders)
results from a ballooned, weakened arterial wall.
An aortic aneurysm is a bulge in the wall of the aorta.
Most aortic aneurysms occur in the abdominal aorta but some occur in the thoracic aorta.
Most aortic aneurysms do not rupture
However, when they do, the resulting hemorrhage is a serious life-threatening emergency.
Etiology:
Most causes of aneurysms are unknown.
One identified risk to developing an aneurysm is atherosclerosis,
hardening of the fatty plaque deposits within the arteries
sometimes associated with a diet high in fat and cholesterol.
Smoking and obesity also increase the risk of atherosclerosis.
Congenital conditions (present from birth) may cause an aneurysm
some individuals are born with weak aortic walls.
A traumatic injury to the chest may also be a risk factor.
Signs and Symptoms:
There are often no signs and symptoms of an aneurysm
Treatment:
surgery to repair the aneurysm.
Thrombophlebitis (circulation disorders)
is a condition in which a thrombus and inflammation develop in a vein.
Etiology:
The causes and risk factors include
prolonged inactivity
oral contraceptives
postmenopausal hormone replacement therapy
some cancers
paralysis in the arms or legs
the presence of a venous catheter
family history of this condition
varicose veins
enlarged, twisted veins
trauma to veins
Signs and Symptoms:
The most common symptoms are
tenderness and pain in the affected area
redness
swelling
tenseness of the affected areas
fever;
a positive Homan’s sign.
A positive sign is present when there is pain in the calf or popliteal region when the foot is dorsiflexed with the knee flexed to 90 degrees.
Treatment:
This disorder is treated by
the application of heat to the affected area
elevation of the legs
anti-inflammatory drugs
anticoagulant medications
the wearing of support stockings
removal of varicose veins
Surgery to remove the clot may be needed in some cases.
Varicose veins (circulation disorders)
are tortuous or twisted, dilated veins that are usually seen in the legs.
when they occur in the rectum, they are called hemorrhoids.
Etiology:
may be caused by
prolonged sitting or standing
damage to valves in the veins
a loss of elasticity in the veins
obesity
pregnancy
use of oral contraceptives
hormone replacement therapy.
Family history also seems to play a part in the development of varicose veins.
Signs and Symptoms:
discomfort in the legs
discoloration around the ankles
clusters of veins
enlarged dark veins that are seen through the skin.
Treatment:
sclerotherapy
a medical procedure that treats varicose and spider veins by injecting a solution that scars and closes the vein.
laser surgery
vein stripping
endoscopic vein surgery to close off affected veins.
Veins Used for Blood Collection
The three veins in the anti-cubital area are the first choice for blood collection
The median cubital vein
is the first choice for blood collection
usually large, visible, well anchored and does not bruise easily.
It’s a superficial vein, most commonly used for venipuncture
it lies over the cubital fossa and serves as an anastomosis between the cephalic and basilic veins.
The cephalic vein
is the second choice for blood collection.
This vein is not as well anchored and is usually more difficult to find.
It can be followed proximally where it empties into the axillary vein.
The basilic vein
is the third choice for blood collection
should only be considered if the median cubital and cephalic veins in both arms have been ruled out.
It is a high-risk area due to the proximity of nerves.
In addition, this vein tends to roll away and bruise more easily.
It divides to join the brachial vein.

Arteries Used for Blood Collection (see diagram)
Doctors and respiratory technologist draw Blood Gas Samples from arteries.
MLA/T’s do not do the procedure as it is outside their legal scope of practice in Canada.
The sample can be obtained either through a catheter placed in an artery, or by using a needle and syringe to puncture an artery.
These syringes are pre-heparinized and handled to minimize air exposure that will alter the blood gas values.
The first choice is the radial artery, which is located on the thumb side of the wrist
because of its small size
use of this artery requires extensive skill in arterial blood sampling.
Alternative sites for access are
brachial arteries
femoral arteries

The Heart
size of a fist
hollow cone shaped heart
weights about 250-350 grams
pumps several thousand gallons of blood in a day and several millions of gallons each year
The cardiovascular system consists
consists of the
heart (a pump)
the vascular system
(a collection of pipes making up a plumbing system).
The main function of this system is to
supply oxygen and nutrients to the tissues of the body
to remove carbon dioxide and waste products.
Location of the heart
Lies behind the sternum
just slightly to the left of midline of the body
occupies a space called the thoracic mediastinum (middle septum) that is
located between the right and left lungs.
The heart extends from the level of the second rib to about the level of the sixth rib.
Inferiorly, the heart rests on the diaphragm.
The heart has
four borders
superior
inferior
medial, lateral
three surfaces
sternocostal
diaphragmatic
pulmonary
The superior border is called the base and is wider than the inferior surface which is called the apex.

Chambers of the heart
There are two atria that sit on two ventricles.
Right and left atrium (receiving chambers)
Right and left ventricle (pumping chamber)
Atria are separated by a septum or wall called the interatrial septum
the ventricles are separated by a wall called the interventricular septum.
There is also a septum that separates the atria from the ventricles, the atrioventricular septum.
The right atrium receives blood that is returning from the body to the heart and blood from the coronary sinus.
The right ventricle receives blood from the right atrium.
The left atrium forms most of the base of the heart.
Four pulmonary veins carrying oxygenated blood enter the left atrium.
The left ventricle receives blood from the left atrium.
works harder than any other chamber because it pumps oxygenated blood out of the heart via the aorta into the systemic circulation.
Its myocardium is twice as thick as that of the right ventricle.

Valves of the heart
make blood flow in one direction
Tricuspid valve
(also called the right AV or atrioventricular valve)
located between the right atrium and right ventricle.
named because
the valve consists of three cusps or leaflets
These three cusps together prevent blood from flowing back into the right atrium
when the right ventricle contracts.
The cusps of this valve are anchored by cordlike structures called chordae tendinae
to specialized cardiac muscle called papillary muscles.
These muscles contract when the ventricles contract.

Pulmonary semilunar valve:
It is situated between the right ventricle and the trunk of the pulmonary arteries.

The bicuspid valve
This valve is also known as the mitral valve or the left AV valve.
has two cusps
is located between the left atrium and the left ventricle.
Like the tricuspid valve
the bicuspid valve also has chordae tendinae attached to papillary muscles.

The aortic semilunar valve
is positioned between the left ventricle and the aorta.

Layers of the heart
endocardium
The innermost layer
It is very thin and lined with endothelium.
muscular myocardium
The middle layer
makes up over 90 percent of the heart.
It is the myocardium that is responsible for the pumping action of the heart.
epicardium
The outermost layer
also known as the visceral pericardium
it contains fat,
helps cushion the heart if the chest experiences blunt trauma.

Pericardium
The entire membrane around the heart
covers the heart and the large blood vessels attached to it.
2 layers
consists of an outer fibrous layer
called the parietal pericardium
an innermost layer
called the visceral pericardium
which lies directly on top of the heart.
Together, the visceral and parietal pericardia (plural) form the pericardial sac.
A very small amount of serous (watery) fluid is found with the sac and acts to reduce friction between the two membranes.


Pulmonary circulation (memorize the flow)
is referred to as the low-pressure circuit
because the blood pressure here is normally only one-eighth of that in the systemic circuit.
The purpose of this circuit is to take deoxygenated blood to the lungs and exchange carbon dioxide for oxygen.
The blood returning to the heart is oxygenated blood.
The route of the pulmonary circuit can be summarized as follows:
right atrium
through the tricuspid valve into the right ventricle
through the pulmonary semilunar valve into the pulmonary trunk
into the pulmonary arteries
into the lungs
into pulmonary veins
finally into the left atrium.


Systemic circulation (memorize the flow)
is referred to as the high-pressure circuit
because the pressure is much greater than that seen in the lungs.
The function of this circuit is to deliver oxygen and nutrients to body cells.
It also picks up carbon dioxide and waste products from body cells.
The systemic circuit can be summarized as follows:
left atrium through the bicuspid valve
into the left ventricle
through the aortic semilunar valve
into the aorta
to the systemic arteries
to arterioles
to capillaries
to venules
to veins
to the superior and inferior venae cavae
into the right atrium of the heart.

Cardiac Cycle
Number of cardiac cycles per minute is the same as the heart rate (pulse rate).
One heartbeat = one cardiac cycle
two heart sounds (lubb and dubb) when valves in the heart shut.
Lubb
First sound - When the ventricles contract, the tricuspid and bicuspid valves snap shut
Dubb
Second sound - When the atria contract and the pulmonary and aortic valves snap shut
is influenced by
exercise
parasympathetic nerves
sympathetic nerves
cardiac control center
body temperature
potassium ions and calcium ions.

In One heart beat
Atria contract and relax
Ventricles contract and relax
Right ventricle contracts
Tricuspid valve closes
Pulmonary semilunar valve opens
Blood flows into pulmonary artery
Left atrium contracts
Bicuspid valve opens
Blood fills left ventricle
Left ventricle contracts
Bicuspid valve closes
Aortic semilunar valve opens
Blood pushed into aorta

Blood Pressure
Force blood exerts on the inner walls of blood vessels
Highest in arteries
Lowest in veins
Systolic pressure
Ventricles contract
Blood pressure is at its greatest in the arteries
Reported as the systolic number over the diastolic number.
Control based mainly on the amount of blood pumped out of the heart.
The amount of blood entering should equal the amount pumped from the heart.
Diastolic pressure
Ventricles relax
Blood pressure in arteries is at its lowest
Myocardial infarction (MI) (common heart disorders)
Commonly called a heart attack
caused by blockage of coronary arteries
often causes death of the individual.
The pain associated with a heart attack is often described as pressure or fullness in the chest.
An “infarction” is death of tissue due to deprivation of oxygen and it can occur in various organs.
the cardiac muscle sustains damage because of the resulting ischemia.
Heart tissue that dies in an MI does not regenerate.
It is a permanent situation that can affect the efficiency of the heart for the rest of the patient’s life.
Etiology:
caused by obstruction of the coronary arteries as a result of
atherosclerosis
a thrombus
blot clot in heart
an embolus.
blod clot in blood stream
Signs and Symptoms:
recurring squeezing chest pain
pain in the
shoulder
arm
back
teeth
jaw
chronic pain in the upper abdomen
shortness of breath, especially on exertion;
diaphoresis
excessive, abnormal sweating
dizziness or fainting
and nausea or vomiting.
Treatment:
The first treatment, if possible, is chewing an aspirin at the onset of symptoms.
Aspirin can help begin to break up blood clots which will allow essential oxygen to get to the myocardium.
In an unconscious patient without a pulse or respiration, CPR should be administered.
Other treatment options include the use of an AED and thrombolytic drugs
to destroy the blood clots that block a coronary artery.
Anticoagulant medications, such as heparin and warfarin (Coumadin)
should be administered to thin the blood
medications that slow the heart rate
such as atenolol.
Angioplasty or coronary artery bypass graft
to open up the coronary arteries are also treatment options.
infarction
is death of tissue due to deprivation of oxygen and it can occur in various organs.
Arrhythmias: (common heart disorders)
Also known as dysrrhythmias are abnormal heart rhythms or rates.
Etiology:
These abnormal rhythms usually result when the electrical impulses of the cardiac conduction system do not travel correctly through the heart.
The list of risk factors and causes is long.
Signs and Symptoms:
dyspnea
Shortness of breath
dizziness or fainting
an uncharacteristically rapid or slow heart rate
a fluttering feeling in the chest, and chest pain.
Treatment:
The first management of arrhythmias should be to treat the underlying cause.
Other treatment options include
pacemakers
medications
cardiopulmonary resuscitation
vagal maneuvers
electrical shock
radiofrequency catheter ablation
implantable cardioverter defibrillator
Maze procedure
surgery to correct heart defects.
Congestive heart failure: (CHF) (common heart disorders)
failure of the heart to pump effectively.
The heart weakens and eventually loses its ability to supply blood to the body.
Etiology:
Many risk factors exist for this condition, including
smoking
overweight
a diet high in fats and cholesterol
a lack of exercise
atherosclerosis
a history of MI
hypertension
a damaged heart valve
excessive alcohol consumption
diabetes mellitus.
Congenital heart defects
drugs that weaken the heart
Signs and Symptoms:
left-sided heart failure include
lightheadedness
kidney failure
shortness of breath
pulmonary hypertension
cough.
right-sided heart failure include
fluid accumulation
edema of the
feet
ankles
liver
abdomen.
The patient may experience nausea and loss of appetite which can lead to cachexia.
muscle mass loss with or without fat mass loss
Treatment:
medications to slow a rapid heartbeat
diuretics to decrease edema and fluid accumulation in the lungs
medications to reduce blood pressure
If the heart failure has progressed significantly, procedures such as surgery
to repair defective heart valves or other heart defects
implantation of a cardiac pacemaker
a heart transplant may be warranted.
ECG (tests to diagnose heartfailure)
This test can help determine if someone is experiencing or has experienced a heart attack in the past.
Stress tests (tests to diagnose heartfailure)
are ECGs performed while a patient is exercising or has been given drugs to increase the heart rate.
Chest x-ray:(tests to diagnose heartfailure)
show the size and shape of the lungs and heart
can therefore indicate conditions such as congestive heart failure in which the heart may be enlarged.
Nuclear scan: (tests to diagnose heartfailure)
These scans follow radioactive substances through the blood vessels of the heart and lungs and can reveal narrow or obstructed arteries.
Electron beam computerized tomography (EBCT) (tests to diagnose heartfailure)
This procedure is much like a CT scan of the arteries and is useful for finding narrowed arteries.
Coronary catheterization: (tests to diagnose heartfailure)
This procedure uses a contrast medium that is followed through coronary arteries.
Echocardiogram (tests to diagnose heartfailure)
This procedure uses sound waves to visualize the shape or defects of the heart.
Endoscopy (tests to diagnose heartfailure)
This procedure involves inserting a tube with a tiny camera down the throat and into the stomach.
Holter Monitor (tests to diagnose heartfailure)
A device that is worn to measure your heart’s activity throughout your normal day.